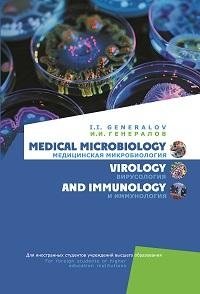
Медицинская микробиология, вирусология и иммунология. Medical Microbiology, Virology and Immunology. ГРИФ фото книги

Медицинская микробиология, вирусология и иммунология. Medical Microbiology, Virology and Immunology. ГРИФ
132.21
BYN
Доставка в Минск:
15 Января (Чт) - 16 Января (Пт)
Доставка в регионы:
19 Января (Пн) - 21 Января (Ср)
Учебное пособие представляет собой всесторонний обзор ключевых разделов медицинской микробиологии, вирусологии и иммунологии. Настоящее издание охватывает все основные разделы дисциплины: общую микробиологию, медицинскую иммунологию, медицинскую бактериологию, медицинскую вирусологию.
Для иностранных студентов учреждений высшего образования, обучающихся на английском языке.
Артикул
u593
Издательство
Тип обложки
твердая обложка
Автор
Штрих код
9789853402506
Год
2025
Страниц
511
Язык
английский
Размеры
170х240 мм
Вес
800 гр.
Изготовитель
РУП «Издательство "Вышэйшая школа"», РБ, г. Минск, пр. Победителей, д. 11
Предмет

Будьте первыми, кто оставит отзыв!